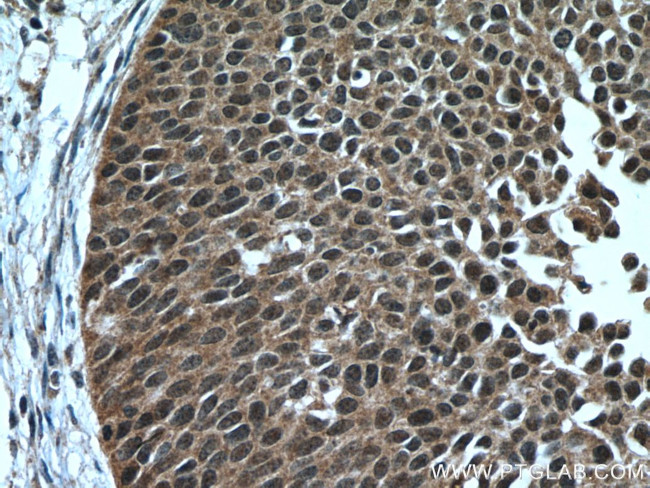
RMND5A Antibody in Immunohistochemistry (Paraffin) (IHC (P))

Search
Proteintech
RMND5A Polyclonal Antibody
{{$productOrderCtrl.translations['antibody.pdp.commerceCard.promotion.promotions']}}
{{$productOrderCtrl.translations['antibody.pdp.commerceCard.promotion.viewpromo']}}
{{$productOrderCtrl.translations['antibody.pdp.commerceCard.promotion.promocode']}}: {{promo.promoCode}} {{promo.promoTitle}} {{promo.promoDescription}}. {{$productOrderCtrl.translations['antibody.pdp.commerceCard.promotion.learnmore']}}
产品信息
17559-1-AP
种属反应
宿主/亚型
分类
类型
抗原
偶联物
形式
浓度
规格
纯化类型
保存液
内含物
保存条件
运输条件
产品详细信息
Immunogen sequence: MDQCVTVER ELEKVLHKFS GYGQLCERGL EELIDYTGGL KHEILQSHGQ DAELSGTLSL VLTQCCKRIK DTVQKLASDH KDIHSSVSRV GKAIDKNFDS DISSVGIDGC WQADSQRLLN EVMVEHFFRQ GMLDVAEELC QESGLSVDPS QKEPFVELNR ILEALKVRVL RPALEWAVSN REMLIAQNSS LEFKLHRLYF ISLLMGGTTN QREALQYAKN FQPFALNHQK DIQVLMGSLV YLRQGIENSP YVHLLDANQW ADICDIFTRD ACALLGLSVE SPLSVSFSAG CVALPALINI KAVIEQRQCT GVWNQKDELP IEVDLGKKCW YHSIFACPIL RQQTTDNNPP MKLVCGHIIS RDALNKMFNG SKLKCPYCPM EQSPGDAKQI FF (1-391 aa encoded by BC047668)
靶标信息
RMND5A is a protein coding gene.
仅用于科研。不用于诊断过程。未经明确授权不得转售。
生物信息学
蛋白别名: 44-kD protein coding for CTLH motif; C-terminal to LisH motif, 44 kDa; E3 ubiquitin-protein transferase RMND5A; FLJ13910; GID complex subunit 2 homolog A; P44CTLH; Protein RMD5 homolog A; unnamed protein product
基因别名: CTLH; GID2; GID2A; p44CTLH; RMD5; RMND5A
UniProt ID: (Human) Q9H871
Entrez Gene ID: (Human) 64795